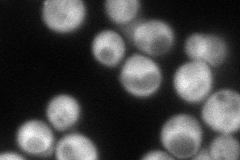
YGL050W
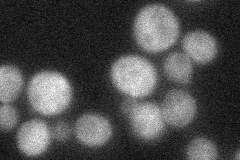
YGL050W

View description
tRNA methyltransferase required for synthesis of wybutosine, a modified guanosine found at the 3'-position adjacent to the anticodon of phenylalanine tRNA which supports reading frame maintenance by stabilizing codon-anticodon interactions
Localization:
Intensity:
Fold change:
Significance:
-
C’ GFP library in SD

below threshold20.67 -
N' NOP1pr-GFP in SD
cytosol92.7504 -
N' TEF2pr-mCherry in SD

cytosol124.557 -
N' NATIVEpr-GFP in SD
cytosol37.8562 -
N' TEF2pr-VC and Cyto-VN in SD

cytosol48.89 -
C’ GFP library in SD+DTT

cytosol23.281.12No -
C’ GFP library in SD+H2O2

cytosol22.361.08No -
C’ GFP library in Starvation Media

cytosol18.550.89No -
C’ GFP library on the background of Pup2-DaMP

below threshold -
C’ GFP library on the background of CCT mutant

below threshold24.2891.1744No
